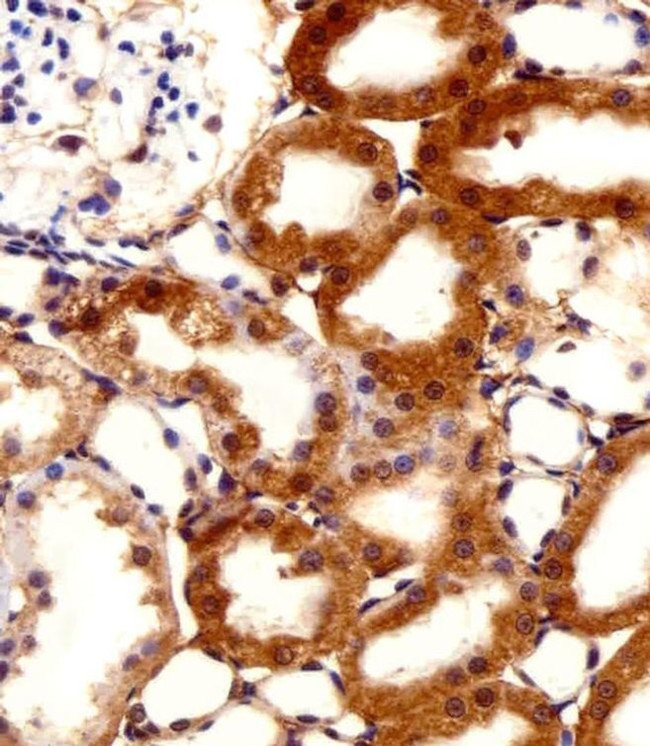
FBXL17 Isoform 2 Antibody in Immunohistochemistry (Paraffin) (IHC (P))

Search
Invitrogen
FBXL17 Isoform 2 Polyclonal Antibody
{{$productOrderCtrl.translations['antibody.pdp.commerceCard.promotion.promotions']}}
{{$productOrderCtrl.translations['antibody.pdp.commerceCard.promotion.viewpromo']}}
{{$productOrderCtrl.translations['antibody.pdp.commerceCard.promotion.promocode']}}: {{promo.promoCode}} {{promo.promoTitle}} {{promo.promoDescription}}. {{$productOrderCtrl.translations['antibody.pdp.commerceCard.promotion.learnmore']}}
图: 1 / 5
FBXL17 Isoform 2 Antibody (PA5-49340) in IHC (P)





产品信息
PA5-49340
宿主/亚型
分类
类型
抗原
偶联物
形式
浓度
保存条件
运输条件
RRID
靶标信息
Members of the F-box protein family, such as FBXL17, are characterized by an approximately 40-amino acid F-box motif. SCF complexes, formed by SKP1 (MIM 601434), cullin (see CUL1; MIM 603134), and F-box proteins, act as protein-ubiquitin ligases. F-box proteins interact with SKP1 through the F box, and they interact with ubiquitination targets through other protein interaction domains (Jin et al., 2004 [PubMed 15520277]).
仅用于科研。不用于诊断过程。未经明确授权不得转售。